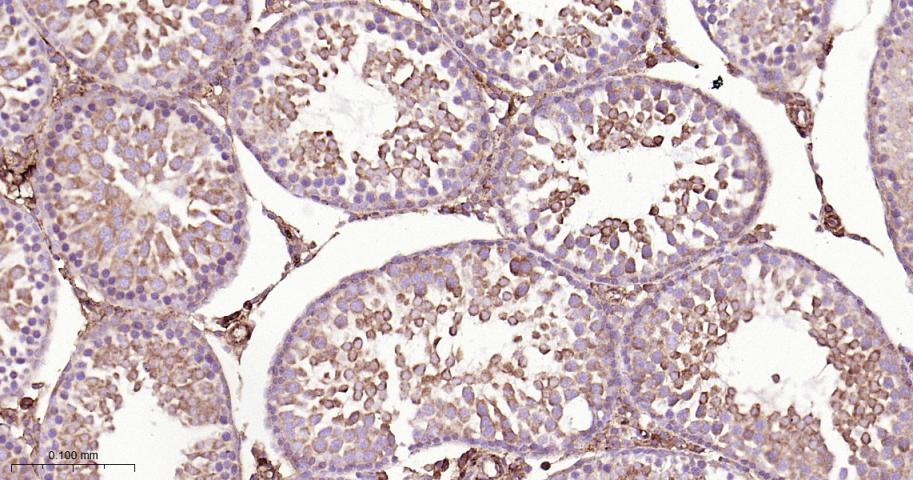
B Raf重组兔单抗

B Raf重组兔单抗
Rrmab?兔单抗

货号:bsm-63118R
产品详情
相关标记
相关产品
相关文献
常见问题
概述
产品编号
bsm-63118R
产品类型
重组兔单抗
英文名称
BRAF Recombinant Rabbit mAb
中文名称
B Raf重组兔单抗
英文别名
B-RAF1; B-raf; BRAF-1; BRAF1; NS7; RAFB1; 9930012E13Rik; Braf-2; Braf2; C230098H17; D6Ertd631e; BRAF_HUMAN; BRAF; Proto-oncogene B-Raf; p94; v-Raf murine sarcoma viral oncogene homolog B1; 2.7.11.1; BRAF_MOUSE;
抗体来源
Rabbit
免疫原
A synthesized peptide derived from human B Raf: 60-100/766
亚型
IgG
性状
Liquid
纯化方法
affinity purified by Protein A
克隆类型
Recombinant
克隆号
4F3
理论分子量
84 kDa
检测分子量
85 kDa
储存液
10mM phosphate buffered saline(pH 7.4) with 150mM sodium chloride, 0.05% BSA, 0.02% Proclin300 and 50% glycerol.
研究领域
Cancer > Oncoproteins/suppressors > Oncoproteins > Signal transducers
Cell Biology > Apoptosis > Intracellular > Kinases
Cell Biology > Cell Cycle > Cell differentiation
Signal Transduction > Protein Phosphorylation > Ser / Thr Kinases > Other Kinases
Signal Transduction > Protein Phosphorylation > Tyrosine Kinases
SWISS
Gene ID
保存条件
Store at 4℃ for short term. Store at -20℃ for long term. Avoid repeated freeze/thaw cycles.
注意事项
This product as supplied is intended for research use only, not for use in human, therapeutic or diagnostic applications.
数据库链接
产品介绍
BRAF蛋白是有丝分裂原活化的蛋白激酶/细胞外信号调节激酶途径蛋白。正常的B-Raf蛋白的功能是传递来自细胞膜的信号,在Ras-Raf-MEK-ERK信号转导调节途径中有着重要的作用.
BRAF是在癌细胞的生长和存活中起到关键作用的蛋白质,并且在大多数恶性黑素瘤患者和少数结肠癌、乳腺癌和肺癌患者中发生突变,目前BRAF也用于恶性黑素瘤和肿瘤的研究。
BRAF是在癌细胞的生长和存活中起到关键作用的蛋白质,并且在大多数恶性黑素瘤患者和少数结肠癌、乳腺癌和肺癌患者中发生突变,目前BRAF也用于恶性黑素瘤和肿瘤的研究。
背景资料
Protein kinase involved in the transduction of mitogenic signals from the cell membrane to the nucleus (Probable). Phosphorylates MAP2K1, and thereby activates the MAP kinase signal transduction pathway.

产品应用
| 应用 | 已检合格种属 | 预测种属 | 推荐稀释比例 |
|---|---|---|---|
| WB | Human | Mouse, Rat | 1:500-2000 |
| IHC-P | Human, Mouse, Rat | 1:50-200 | |
| IHC-F | Human, Mouse, Rat | 1:50-200 | |
| IF | Human, Mouse, Rat | 1:50-200 | |
| Flow-Cyt | Human, Mouse, Rat | 1:50-100 | |
| ICC/IF | Human | Mouse, Rat | 1:50-200 |
| IP | Human, Mouse, Rat | 1:20-50 |
交叉反应
交叉反应: Human, Mouse, Rat
相关产品
暂无相关产品
靶标
基因名
BRAF
蛋白名
Serine/threonine-protein kinase B-raf
亚基
Monomer. Homodimer. Heterodimerizes with RAF1, and the heterodimer possesses a highly increased kinase activity compared to the respective homodimers or monomers. Heterodimerization is mitogen-regulated and enhanced by 14-3-3 proteins. MAPK1/ERK2 activation can induce a negative feedback that promotes the dissociation of the heterodimer by phosphorylating BRAF at Thr-753. Found in a complex with at least BRAF, HRAS1, MAP2K1, MAPK3 and RGS14. Interacts with RIT1. Interacts (via N-terminus) with RGS14 (via RBD domains); the interaction mediates the formation of a ternary complex with RAF1, a ternary complex inhibited by GNAI1. Interacts with DGKH.
亚细胞定位
Nucleus. Cytoplasm. Cell membrane.
组织特异性
Brain and testis.
翻译后修饰
Phosphorylation at Ser-365 by SGK1 inhibits its activity.
Methylation at Arg-671 decreases stability and kinase activity.
Ubiquitinated by RNF149; which leads to proteasomal degradation.
Methylation at Arg-671 decreases stability and kinase activity.
Ubiquitinated by RNF149; which leads to proteasomal degradation.
疾病
Note=Defects in BRAF are found in a wide range of cancers.
Defects in BRAF may be a cause of colorectal cancer (CRC) [MIM:114500].
Defects in BRAF are involved in lung cancer (LNCR) [MIM:211980]. LNCR is a common malignancy affecting tissues of the lung. The most common form of lung cancer is non-small cell lung cancer (NSCLC) that can be divided into 3 major histologic subtypes: squamous cell carcinoma, adenocarcinoma, and large cell lung cancer. NSCLC is often diagnosed at an advanced stage and has a poor prognosis.
Defects in BRAF are involved in non-Hodgkin lymphoma (NHL) [MIM:605027]. NHL is a cancer that starts in cells of the lymph system, which is part of the body's immune system. NHLs can occur at any age and are often marked by enlarged lymph nodes, fever and weight loss.
Defects in BRAF are a cause of cardiofaciocutaneous syndrome (CFC syndrome) [MIM:115150]; also known as cardio-facio-cutaneous syndrome. CFC syndrome is characterized by a distinctive facial appearance, heart defects and mental retardation. Heart defects include pulmonic stenosis, atrial septal defects and hypertrophic cardiomyopathy. Some affected individuals present with ectodermal abnormalities such as sparse, friable hair, hyperkeratotic skin lesions and a generalized ichthyosis-like condition. Typical facial features are similar to Noonan syndrome. They include high forehead with bitemporal constriction, hypoplastic supraorbital ridges, downslanting palpebral fissures, a depressed nasal bridge, and posteriorly angulated ears with prominent helices. The inheritance of CFC syndrome is autosomal dominant.
Defects in BRAF are the cause of Noonan syndrome type 7 (NS7) [MIM:613706]. Noonan syndrome is a disorder characterized by facial dysmorphic features such as hypertelorism, a downward eyeslant and low-set posteriorly rotated ears. Other features can include short stature, a short neck with webbing or redundancy of skin, cardiac anomalies, deafness, motor delay and variable intellectual deficits.
Defects in BRAF are the cause of LEOPARD syndrome type 3 (LEOPARD3) [MIM:613707]. LEOPARD3 is a disorder characterized by lentigines, electrocardiographic conduction abnormalities, ocular hypertelorism, pulmonic stenosis, abnormalities of genitalia, retardation of growth, and sensorineural deafness.
Note=A chromosomal aberration involving BRAF is found in pilocytic astrocytomas. A tandem duplication of 2 Mb at 7q34 leads to the expression of a KIAA1549-BRAF fusion protein with a constitutive kinase activity and inducing cell transformation.
Defects in BRAF may be a cause of colorectal cancer (CRC) [MIM:114500].
Defects in BRAF are involved in lung cancer (LNCR) [MIM:211980]. LNCR is a common malignancy affecting tissues of the lung. The most common form of lung cancer is non-small cell lung cancer (NSCLC) that can be divided into 3 major histologic subtypes: squamous cell carcinoma, adenocarcinoma, and large cell lung cancer. NSCLC is often diagnosed at an advanced stage and has a poor prognosis.
Defects in BRAF are involved in non-Hodgkin lymphoma (NHL) [MIM:605027]. NHL is a cancer that starts in cells of the lymph system, which is part of the body's immune system. NHLs can occur at any age and are often marked by enlarged lymph nodes, fever and weight loss.
Defects in BRAF are a cause of cardiofaciocutaneous syndrome (CFC syndrome) [MIM:115150]; also known as cardio-facio-cutaneous syndrome. CFC syndrome is characterized by a distinctive facial appearance, heart defects and mental retardation. Heart defects include pulmonic stenosis, atrial septal defects and hypertrophic cardiomyopathy. Some affected individuals present with ectodermal abnormalities such as sparse, friable hair, hyperkeratotic skin lesions and a generalized ichthyosis-like condition. Typical facial features are similar to Noonan syndrome. They include high forehead with bitemporal constriction, hypoplastic supraorbital ridges, downslanting palpebral fissures, a depressed nasal bridge, and posteriorly angulated ears with prominent helices. The inheritance of CFC syndrome is autosomal dominant.
Defects in BRAF are the cause of Noonan syndrome type 7 (NS7) [MIM:613706]. Noonan syndrome is a disorder characterized by facial dysmorphic features such as hypertelorism, a downward eyeslant and low-set posteriorly rotated ears. Other features can include short stature, a short neck with webbing or redundancy of skin, cardiac anomalies, deafness, motor delay and variable intellectual deficits.
Defects in BRAF are the cause of LEOPARD syndrome type 3 (LEOPARD3) [MIM:613707]. LEOPARD3 is a disorder characterized by lentigines, electrocardiographic conduction abnormalities, ocular hypertelorism, pulmonic stenosis, abnormalities of genitalia, retardation of growth, and sensorineural deafness.
Note=A chromosomal aberration involving BRAF is found in pilocytic astrocytomas. A tandem duplication of 2 Mb at 7q34 leads to the expression of a KIAA1549-BRAF fusion protein with a constitutive kinase activity and inducing cell transformation.
相似性
Belongs to the protein kinase superfamily. TKL Ser/Thr protein kinase family. RAF subfamily.
Contains 1 phorbol-ester/DAG-type zinc finger.
Contains 1 protein kinase domain.
Contains 1 RBD (Ras-binding) domain.
Contains 1 phorbol-ester/DAG-type zinc finger.
Contains 1 protein kinase domain.
Contains 1 RBD (Ras-binding) domain.
功能
Involved in the transduction of mitogenic signals from the cell membrane to the nucleus. May play a role in the postsynaptic responses of hippocampal neuron.
标记抗体
暂无标记数据
同靶标产品
暂无同靶标产品
相关文献
提示: 发表研究结果有使用 bsm-63118R 时请让我们知道,以便我们可以引用参考文章。作为回馈,资料提供者将获得我们送上的小礼品。
暂无相关文献
常见问题
暂无常见问题